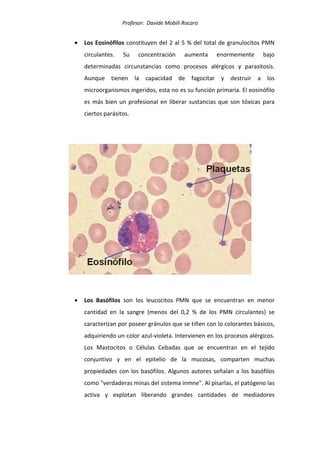
Profesor: Davide Mobili Rocaro
• Los Eosinófilos constituyen del 2 al 5 % del total de granulocitos PMN
circulantes. Su concentración aumenta enormemente bajo
determinadas circunstancias como procesos alérgicos y parasitosis.
Aunque tienen la capacidad de fagocitar y destruir a los
microorganismos ingeridos, esta no es su función primaria. El eosinófilo
es más bien un profesional en liberar sustancias que son tóxicas para
ciertos parásitos.
• Los Basófilos son los leucocitos PMN que se encuentran en menor
cantidad en la sangre (menos del 0,2 % de los PMN circulantes) se
caracterizan por poseer gránulos que se tiñen con lo colorantes básicos,
adquiriendo un color azul-violeta. Intervienen en los procesos alérgicos.
Los Mastocitos o Células Cebadas que se encuentran en el tejido
conjuntivo y en el epitelio de la mucosas, comparten muchas
propiedades con los basófilos. Algunos autores señalan a los basófilos
como "verdaderas minas del sistema inmne". Al pisarlas, el patógeno las
activa y explotan liberando grandes cantidades de mediadores

Este documento presenta información sobre las células del sistema inmune, incluyendo las células del sistema fagocítico mononuclear como monocitos y macrófagos, granulocitos como neutrófilos, eosinófilos y basófilos, células presentadoras de antígeno, y plaquetas. Describe las funciones de estas células, como la fagocitosis, presentación de antígenos, y hemostasia. El profesor Davide Mobili Rocaro provee esta guía de estudio sobre inmunología para la Facult